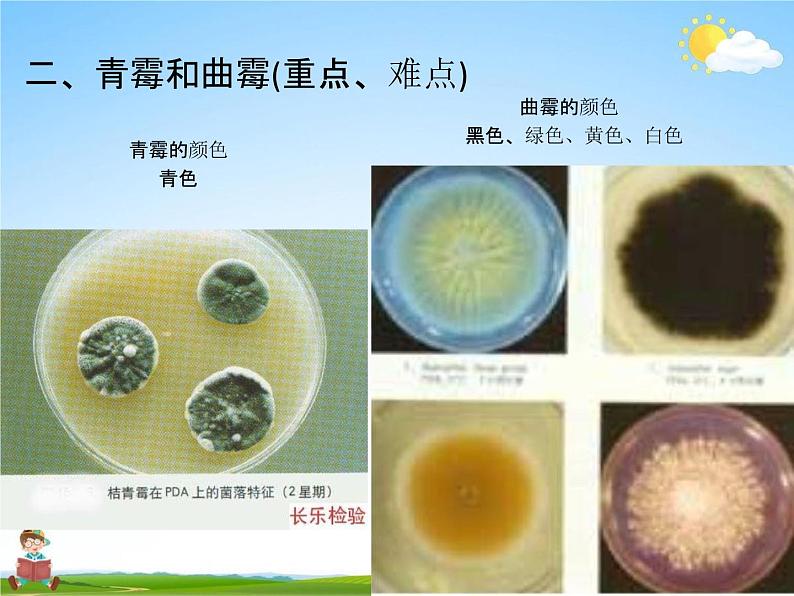

人教版 (新课标)八年级上册第三节 真菌教学课件ppt
展开
这是一份人教版 (新课标)八年级上册第三节 真菌教学课件ppt,共20页。PPT课件主要包含了身边的故事,各种各样的真菌,酵母菌,身边的故事霉菌,及时反馈1,及时反馈2,课堂小结,叶绿体等内容,欢迎下载使用。
南方6月梅雨季节,气温高, 空气非常潮湿,闷热,正值6 月期末复习阶段,宿舍的小 齐拖完地顾不上洗拖把就放 在那里了。一周考试结束后, 看着凌乱的宿舍,我拿起拖 把正想拖地时,很诧异的发 现拖把上长了几个蘑菇,我纳闷:它们是怎么长出来 的?蘑菇的生活环境: 温暖、潮湿、有机物丰富
费了好大的劲把拖把处 理干净后,我们又接着 收拾起柜子,柜子里的 很多食物经过了一个多 星期发生了惊人的变化,甚至让我们觉得有点 恶心,长出了很多毛毛 的东西!我纳闷:食物上的是什 么呢?
黑色、绿色、黄色、白色
二、青霉和曲霉(重点、难点)
游戏道具:气球、细线、针、泡沫
请仔细观察泡沫的散落情况。
三、真菌的繁殖 ——孢子生殖
蘑菇的菌褶里,青霉和曲霉直立菌丝的顶端,生有孢子。孢子可以飘散到各处,每个孢子在适宜的环境条件下,都能发育成一个新个体。
1、吹打发霉物体时,常有粉尘飞扬,这些粉
尘的主要成分是( A.物体上的灰尘 C.霉菌的种子
)B.霉菌的孢子 D.细菌的芽孢
知识点:霉菌的繁殖方式
真菌的主要特征1.形态:有 单细胞的,如酵母菌;多数是 多细胞 的种类,如青霉、曲霉。
2.细胞结构:有 细胞壁
、细胞质 、 细胞膜 和 细胞核 ,
3.生殖方式:都能产生 孢子,它能发育成新个体。 生殖方式为孢子生殖。
真菌、细菌、病毒和动、植物细胞的比较
病毒由蛋白质外壳和遗传物质构成,没有细胞结构。
2、下列对病毒、细菌和真菌的描述,正确的是( A.病毒是由细胞构成的B.真菌都是单细胞生物 C.细菌具有成形的细胞核D.大多数细菌和真菌在生态系统中属于分解者
知识点:病毒、真菌、 细菌的比较
3、橘子发霉会长出大量的青霉菌,霉菌与橘 树叶片细胞的区别是()
A.有无成形的细胞核 C.有无细胞膜
B.有无叶绿体 D.有无细胞结构
知识点:真菌细胞与植物细胞的区别
4、下列各项中,不属于真菌主要特征的是 () A .细胞内不含叶绿素B .细胞内有真正的细胞核 C .能够形成菌柄和菌盖 D .能够产生孢子知识点:真菌的特征
5、平菇一般用棉籽壳栽培,根据这一特点可以 推知蘑菇细胞中不可能含有 ()
A .叶绿体C .细胞质
B .细胞核D .线粒体
知识点:真菌的营养方式
相关课件
这是一份初中生物人教版 (新课标)八年级上册第三节 真菌教案配套课件ppt,共15页。PPT课件主要包含了金针菇,毛霉菌,青霉菌,冬虫夏草,酵母菌,植物细胞,细胞壁,细胞核,细胞膜,细胞质等内容,欢迎下载使用。
这是一份生物八年级上册第三节 真菌备课ppt课件,共14页。PPT课件主要包含了课前回顾,课前思考,羊肚菌,金针菇,猴头菇,真菌的类型,单细胞真菌,酵母菌,多细胞真菌,木耳等等内容,欢迎下载使用。
这是一份人教版 (新课标)八年级上册第一节 尝试对生物进行分类教学ppt课件,共24页。PPT课件主要包含了多种多样的生物,种子植物的分类,一片子叶,没有种子的植物分类,观察分析动物,无脊椎动物分类等内容,欢迎下载使用。
